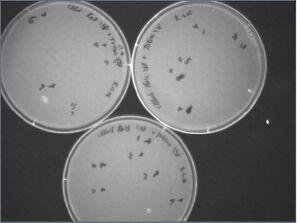

IGEM:Harvard/2006/Cyanobacteria/Notebook/2006-8-16
<html><style type='text/css'> .tabs {
font-size:80%;
font-weight:none;
width: 100%;
color: #FFFFFF;
background:#FFFFFF url("/images/5/54/DarkgreenTab-bg.gif") repeat-x bottom;
}
.tabs li {
background:url("/images/3/36/DarkgeenTab-left.gif") no-repeat left top;
}
.tabs a,.tabs strong {
background:url("/images/d/d3/DarkgreenTab-right.gif") no-repeat right top;
color:#FFFFFF;
padding: 3px 10px 3px 4px;
}
.tabs strong{
color:#CCFF00;
background-image:url("/images/b/b1/DarkgreenTab-right_on.gif");
}
.tabs a:hover{
color:#66FF00;
}
</style></html>
To-do
- Western blots
Inoculate several cultures of GFP dev. for Western blotting this afternoonTake regular measurements of culture OD- Western blot (delayed until tomorrow because we don't seem to have GFP)
- Construct creation
Restreak and do colony PCRs of the Kai\X-P + J04500\S-P transformants to check if our insert is thereMidiprep the KaiA/B/C in GA plasmid that we grew up from frozen stocks yesterdayDigest a large amount of KaiA/B/C\X-P- Gel-purify
- RBS + KaiC construct
Miniprep the B0034 culturesDigest B0034\S-P- Gel-purify
- Ligate KaiC\X-P + B0034\S-P
- Transform KaiC\X-P + B0034\S-P
Miniprep of B0034
Title says it all; 2 60uL samples of B0034 in the freezer, and glycerol stock.
Inoculation R0010 + E0241
10 inoculations of the R0010 + E0241 were made:
- 10 mL LB amp & 1 ul R0010 + E0241
- 10 mL LB amp & 1 ul R0010 + E0241 (IPTG - not yet added)
- 10 mL LB amp & 8 ul R0010 + E0241
- 10 mL LB amp & 8 ul R0010 + E0241 (IPTG - not yet added)
- 10 mL LB amp & 64 ul R0010 + E0241
- 10 mL LB amp & 64 ul R0010 + E0241 (IPTG - not yet added)
- 10 mL LB amp & 256 ul R0010 + E0241
- 10 mL LB amp & 256 ul R0010 + E0241 (IPTG - not yet added)
- 10 mL LB amp & 4.1 mL R0010 + E0241
- 10 mL LB amp & 4.1 mL R0010 + E0241 (IPTG - not yet added)
Midiprep of KaiABC
The KaiABC genes were eluted (redissolved) in 200 mL of H2O.
- KaiA: 279.1 ng/uL
- KaiB: 285.2 ng/uL
- KaiC: 409.7 ng/uL + 409.5 ng/uL
Ligation test and replating
We had 18 colonies grow up; see the image at the right. For each of these, I plated and did a colony PCR to test for the insert. For the first 8, I also innoculated, though it may not work.
Each reaction:
- 8 µL PCR Supermix
- 1 µL VF2 primers @ 2uM
- 1 µL VR primers @2uM
- colony or 1 uL template or nothing
19 RXNS: (18 + 1 pos, which is B0034)
- 8*20=160uL supermix
- 1*20 = 20uL VF2
- 1*20 = 20uL VR
PCR schedule:
- 95C for 15'00
- Do 30 times:
- 95C for 0'30
- 55C for 0'30
- 72C for 2'00
- 72C for 10'00
- 4C forever
Results:
I'm confused.... the + control is B0034 (the RBS), for reference; the actual coding sequence is i think 33bp or something really short, so basically add on the size of the band in the gel to the expected KaiA,B,and C sizes.
EDIT: Actually, the previous ligation was not a self-ligation like thought. Look at http://www.openwetware.org/wiki/Image:2006_08_14_egel2.jpg, we expect a 550 bp band (like + control) if it self-ligated but it actually is a 300bp band...
EXPECTED
- KaiA from VF to VR2: 855bp + 536bp (VF2-VR on J04500) - 6bp+20bp (prefixes) = 1.4kb
- KaiB: 309bp + 536bp (VF2-VR on J04500) - 6bp+20bp (prefixes) = 859bp
- KaiC: 1560bp + 536bp (VF2-VR on J04500) - 6bp+20bp (prefixes) = 2110bp
- B0034 Positive: 250bp (VF2-VR) = 250bp
- Nothing: 536bp


Innoculation of GFP Device from Nick's Plate
4 Innoculations were made of GFP (R0010 + E0241) from Nick's bright green plate. The cells could be dead, though, so no guarantees. All 4 innoculations were made in 10mL LB + Amp. Also made a negative control of 10mL LB + Amp.
Digest of Kai\X-P and B0034\S-P
| Plasmid | Enzymes | Incubation temperature | Incubation time |
| KaiA in GA | X, P | 37C | 16 hrs |
| KaiB in GA | X, P | 37C | 16 hrs |
| KaiC in GA | X, P | 37C | 16 hrs |
| B0034 in pSB1A2 | S, P | 37C | 16 hrs |
| KaiA in GA | X, P | 45C | 16 hrs |
| KaiB in GA | X, P | 45C | 16 hrs |
| KaiC in GA | X, P | 45C | 16 hrs |
| B0034 in pSB1A2 | S, P | 45C | 16 hrs |
Kai\X-P reactions
- 8 µL midiprepped DNA
- 2.5 µL NEBuffer 3
- 0.5 µL XbaI
- 0.5 µL PstI
- 0.25 µL 100x BSA
- 13.25 µL H2O
Kai\X-P master mix
- 17.5 µL NEBuffer 3
- 3.5 µL XbaI
- 3.5 µL PstI
- 1.75 µL 100x BSA
- 92.75 µL H2O
Pipette 17 µL into each reaction.
B0034\S-P reactions
- 21.25 µL DNA
- 2.5 µL NEBuffer 2
- 0.5 µl SpeI
- 0.5 µL PstI
- 0.25 µL 100x BSA
B0034\S-P master mix
- 10 µL NEBuffer 2
- 2 µL SpeI
- 2 µL PstI
- 1 µL 100x BSA
Pipette 3.75 µL into each reaction.
Digest of J04500 /xp and /sp=
Did 3 digests of J04500 /xp and /sp ea., in 10uL of sol'n as following Silver protocol. 45C for 10h.--Zsun 20:31, 19 August 2006 (EDT)